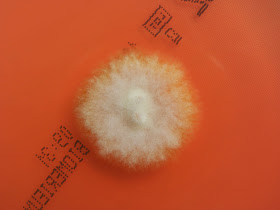

O Trichoderma viride é um fungo filamentoso septado hialino.
Os fungos do género Trichoderma são muito frequentes no solo sobretudo o florestal. Como agentes patogénicos humanos apenas estão descritos raros casos de pneumonia (fungus ball) e peritonite em doentes com diálise peritonial ambulatória.
Esta estirpe foi isolada em secreções brônquicas de uma paciente com asma, este doente teve 2 meses antes outra secreção bronquica com Aspergillus fumigatus.
As colónias crescem muito rapidamente e pelo 4º dia de incubação preenchem toda a placa. Inicialmente a colónia é branca, passando a verde claro e depois a verdxe mais escuro com zonas brancas. O reverso é branco-creme.
Microscopicamente observa-se um conidióforo em pirâmide com ramificações em ângulo recto, curtas no ápex e um pouco maiores na base. As hifas são hialinas e septadas. As fiálides são em forma de jarra com colo curto e estreito. Os conidios são sub-esféricos, rugosos e podem apresentar-se em pequenas massa verdes.
 |
| Colónia com 24 horas de incubação a 30 graus. |
 |
| Reverso da colónia. |
 |
| Colónia com 2 dias de incubação a 30 graus. |
 |
| Colónia com 4 dias de incubação a 30 graus. |
 |
| Reverso da colónia. |